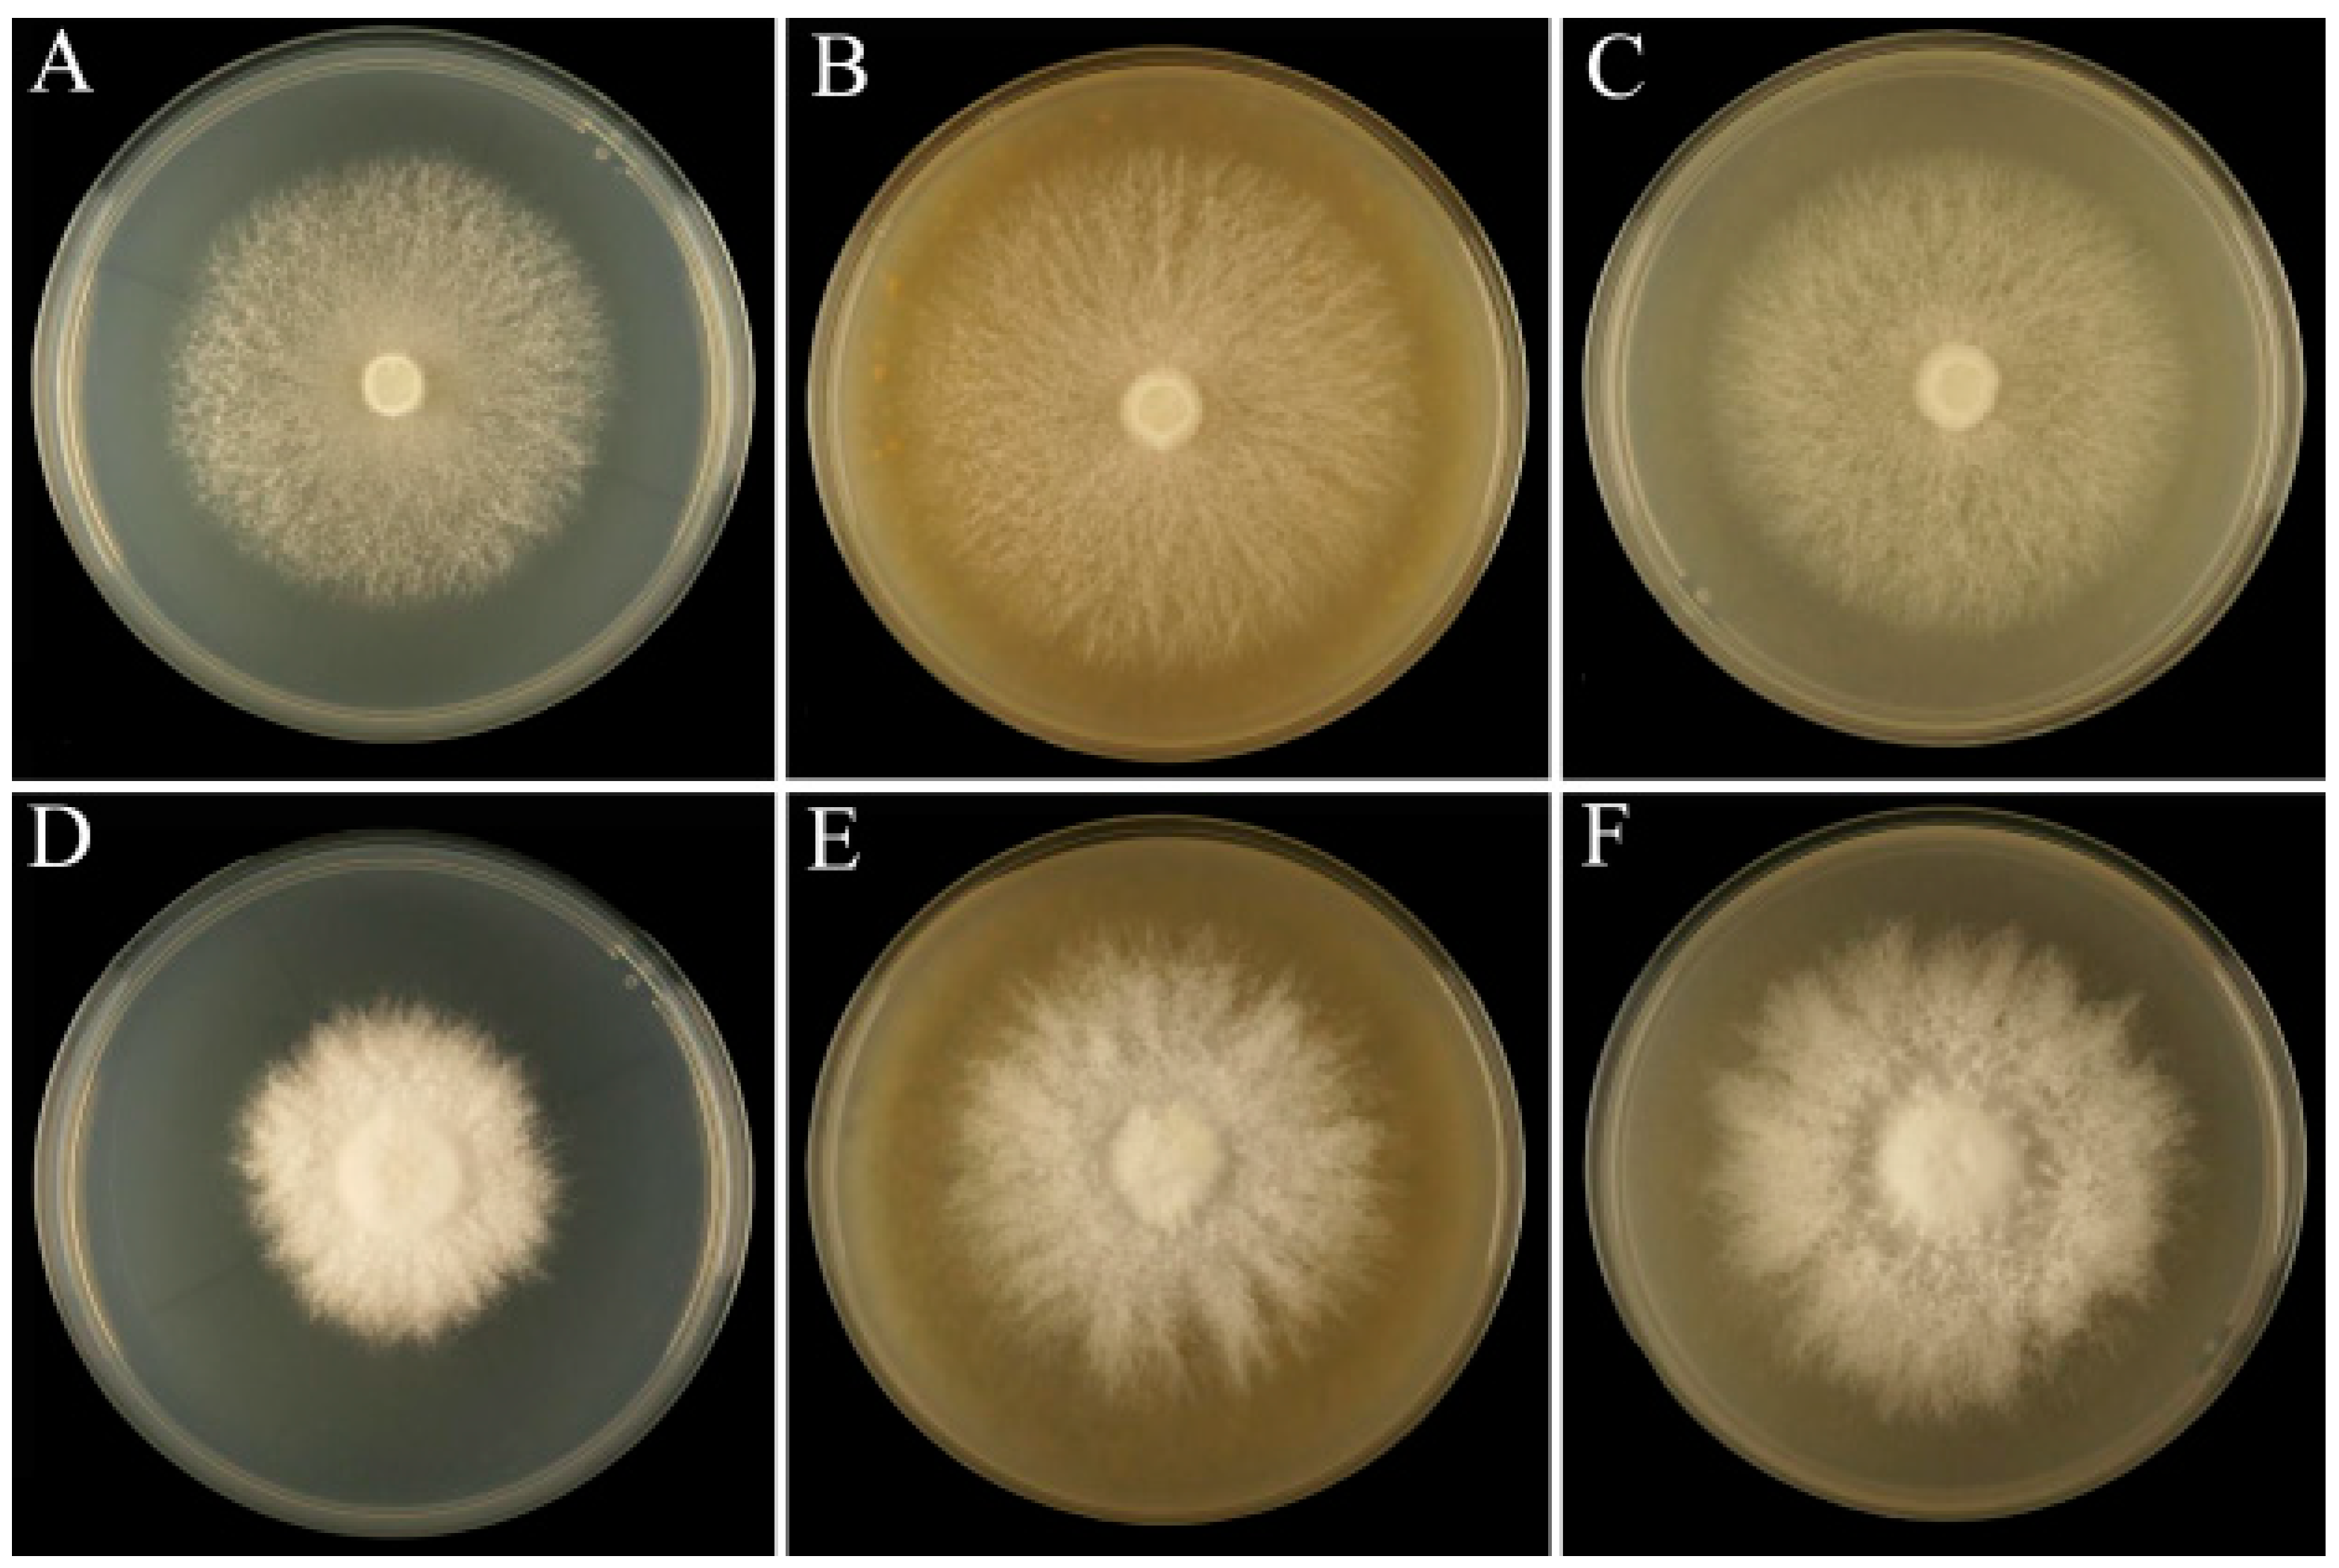
Jof 10 00808 g001

Transcriptome Analysis of the Growth-Promoting Effect of Large Macrofungal Sclerotium Powder on Lentinula edodes and Pleurotus eryngii Strains
Abstract
1. Introduction
2. Materials and Methods
2.1. Fungal Strains and Cultivation
2.2. Determination of Mycelial Growth Rate and DAPI Nuclear Staining
2.3. RNA Extraction, Library Construction, and RNA Sequencing
2.4. Transcriptome Data Analysis
2.5. Selection of Key DEGs and Analysis by Quantitative Real-Time PCR
2.6. Statistical Analysis
3. Results
3.1. Mycelial Growth Rate with Different Added Ratios of Sclerotium Powder
3.2. Microscopic Observation of Mycelial Morphology
3.3. Analysis of DEGs
3.4. Functional Annotation of DEGs
3.5. Expression Analysis of CAZYme Family Genes in DEGs
3.6. Validation of Results by Real-Time Fluorescence Quantitative PCR
4. Discussion
Supplementary Materials
Author Contributions
Funding
Institutional Review Board Statement
Informed Consent Statement
Data Availability Statement
Conflicts of Interest
References
- Imtiaj, A.; Jayasinghe, C.; Lee, G.W.; Lee, T.S. Comparative study of environmental and nutritional factors on the mycelial growth of edible mushrooms. J. Cult. Collect. 2009, 6, 97–105. [Google Scholar]
- Li, J.Y.; Wang, X.Q.; Li, J.C. Comparison of the effect of four parent culture media on rejuvenating Pleurotus eryngii. Edible Fungi 2018, 40, 30–32. [Google Scholar]
- Liu, N.; Song, Y.; Zhang, M.; Lv, L.T.; Zhang, S.Y.; Li, Y. Effect of subculture of Lentinula edodes on mycelial characteristics and microstructure. N. Hortic. 2022, 3, 118–124. [Google Scholar]
- Andlar, M.; Rezic, T.; Mardetko, N.; Kracher, D.; Ludwig, R.; Santek, B. Lignocellulose degradation: An overview of fungi and fungal enzymes involved in lignocellulose degradation. Eng. Life Sci. 2018, 18, 768–778. [Google Scholar] [CrossRef]
- Yuan, S.M.; Fang, L.L.; He, D.; Li, C.X. Identification of a strain of wild Lentinula edodes and study on the optimum growth conditions of its mycelium. J. Hubei Univ. Natl. Nat. Sci. Ed. 2016, 34, 77–80. [Google Scholar]
- Yan, A.F.; Yu, L.; Sun, X. Optimization of carbon source and nitrogen source in mother culture medium of Pleurotus eryngii. J. B. Univ. 2020, 39, 9–12. [Google Scholar]
- Sainos, E.; Diaz-Godinez, G.; Loera, O.; Montiel-Gonzalez, A.M.; Sanchez, C. Growth of Pleurotus ostreatus on wheat straw and wheat-grain-based media: Biochemical aspects and preparation of mushroom inoculum. Appl. Microbiol. Biotecnol. 2006, 72, 812–815. [Google Scholar] [CrossRef]
- Chen, X.F. Research on culture-medium screening and liquid seed production of mushroom. Agric. Res. Apl. 2005, 18, 4–5. [Google Scholar]
- Hu, X.Y.; Li, J.P. The selection on the optimum culture medium of female parent and mother seed of Agaricus blazei Murr. Beijing Agric. 2009, 29, 28–32. [Google Scholar]
- Chen, H.; Liu, Y.; Wang, W.G. Study on primary seed culture medium of Stropharia rugoso-annulata farlow apud murrill. North. Hortic. 2011, 35, 178–179. [Google Scholar]
- Wang, X.L. Comparative test of mother culture medium formulation of Lentinula edodes. Edible Fungi 1996, 21, 19. [Google Scholar]
- Zhao, J.X.; Wang, L.; Qi, Z.G. Screening of four kinds of edible mushroom mother culture medium. Edible Fungi 2003, 28, 18–20. [Google Scholar]
- Hou, D.; Zhou, C.L.; Li, Y.; Yang, R.H.; Bao, D.P. The gene expression profiles of promoting mycelial growth of monokaryotic strains of Lentinula edodes cultured on PDA with additional sawdust. Mycosystema 2023, 42, 507–519. [Google Scholar]
- Hanai, H.; Ishida, S.; Saito, C.; Maita, T.; Kusano, M.; Tamogami, S.; Noma, M. Stimulation of mycelia growth in several mushroom species by rice husks. Biosci. Biotechnol. Biochem. 2005, 69, 123–127. [Google Scholar] [CrossRef] [PubMed]
- Pan, J.P.; Liu, S.Y.; Jiang, N.; Li, X. Effect of peanut hull media on the growth of mycelia of Pleurotus eryngii. J. Fungal Res. 2011, 9, 50–53. [Google Scholar]
- Wang, M. Effect of peanut shell medium on Lentinula edodes mycelia growth. Biotech World 2014, 8, 19–20. [Google Scholar]
- Li, Q.X.; Yuan, J.F.; Zhen, Z.; Qiu, F.T.; Hao, J.W. Optimization experiment of mother culture medium of Lentinula edodes on honeysuckle vine. Edible Fungi 2018, 40, 43–44+65. [Google Scholar]
- Jiang, M.; Wu, Y.Y.; Fu, X.W.; Chen, M.Y. Study on application of Pholiota nameko mushroom residue in edible fungus mother culture medium. North. Hortic. 2014, 38, 140–143. [Google Scholar]
- Yang, J.H.; Li, Z.P.; Zhou, F.; Du, S.T.; Bao, D.P. Study on reuse of fungus bran in factory cultivation of Pleurotus eryngii. Edible Med. Mushrooms 2014, 22, 140–143. [Google Scholar]
- Zhang, Y.; Tian, L.; Xu, M.H.; Wang, P.; Song, B.; Li, Y. Research progress in comprehensive utilization of spent mushroom substrates. Microbiol. China 2020, 47, 3658–3670. [Google Scholar]
- Sun, X.; Liu, D.; Wang, Y.; Ma, A. Biogenesis of macrofungal sclerotia: Influencing factors and molecular mechanisms. Appl. Microbiol. Biotechnol. 2020, 104, 4227–4234. [Google Scholar] [CrossRef] [PubMed]
- Song, H.Y.; Kim, D.H.; Kim, J.M. Comparative transcriptome analysis of dikaryotic mycelia and mature fruiting bodies in the edible mushroom Lentinula edodes. Sci. Rep. 2018, 8, 8983. [Google Scholar] [CrossRef] [PubMed]
- Cao, S.; Yang, Y.; Bi, G.; Nelson, D.; Hu, S.; Makunga, N.P.; Yu, B.; Liu, X.; Li, X.; Hu, X. Genomic and transcriptomic insight of giant sclerotium formation of wood-decay fungi. Front. Microbiol. 2021, 12, 746121. [Google Scholar] [CrossRef] [PubMed]
- Papp, V.; Dai, Y.C. What is the correct scientific name for “Fuling” medicinal mushroom? Mycology 2022, 13, 207–211. [Google Scholar] [CrossRef]
- Liu, P.Y.; Wang, K.; Liang, S.; Li, P.; Du, B. Advances in understanding the structure and biological activity of Poria cocos polysaccharides. Food Sci. 2023, 44, 380–391. [Google Scholar]
- Wang, Y.; Tian, S.S.; Liu, X.Q.; Zhang, Y.X.; Yan, L.H.; Wang, Z.M. Research progress on extraction, structures and pharmacological activities of Poria cocos polysaccharides. World Chin. Med. 2021, 16, 2548–2555. [Google Scholar]
- Jiang, Y.F.; Jin, M.Y.; Zhou, X.W. Research progress on Wolfiporia cocos polysaccharides and their immunoregulatory functions. Acta Edulis Fungi 2021, 28, 130–139. [Google Scholar]
- Yi, J.; Wu, J.Z. Chemical composition analysis of Pleurotus tuber-regium. Chin. Wild Plant Resour. 2000, 19, 38–40. [Google Scholar]
- Weng, B.Q.; Jiang, Z.H.; Bing, W.; Wang, Y.X.; Luo, T.; Lin, Y. Isolation, purification and chemical structure analysis of the sclerotinia proteoglycan of Pleurotus tuber-regium. Acta Edulis Fungi 2006, 13, 61–65. [Google Scholar]
- Yang, Y.B.; Liu, C.H.; Lin, Y.C.; Chen, C.M.; Yi, H.; Yang, S.Y. Advances in research on the edible medicinal fungus Pleurotus tuber-regium. Edible Fungi China 2007, 26, 3–5. [Google Scholar]
- Chen, Z.H.; Yang, R.H.; Wu, Y.Y.; Li, Y.; Tang, L.H.; Guo, T.; Bao, D.P. Effects of two types of large fungal sclerotium powders on the mycelial growth of 11 edible fungi. J. Fungal Res. 2024. [Google Scholar] [CrossRef]
- Nie, J.J.; Pan, B.H.; Li, C.P.; Niu, Y.; Xu, Q.F.; Feng, W.J.; Meng, Q.X. Optimum of stock culture medium formula of Auricularia fuslosuccinea by orthogonal test. Edible Med. Mushrooms 2020, 28, 318–320+327. [Google Scholar]
- Bolger, A.M.; Lohse, M.; Usadel, B. Trimmomatic: A flexible trimmer for Illumina sequence data. Bioinformatics 2014, 30, 2114–2120. [Google Scholar] [CrossRef]
- Kim, D.; Langmead, B.; Salzberg, S.L. HISAT: A fast spliced aligner with low memory requirements. Nat. Methods 2015, 12, 357–360. [Google Scholar] [CrossRef]
- Pertea, M.; Pertea, G.M.; Antonescu, C.M.; Chang, T.C.; Mendell, J.T.; Salzberg, S.L. StringTie enables improved reconstruction of a transcriptome from RNA-seq reads. Nat. Biotechnol. 2015, 33, 290–295. [Google Scholar] [CrossRef]
- Anders, S.; Huber, W. Differential expression analysis for sequence count data. Genome Biol. 2010, 11, R106. [Google Scholar] [CrossRef]
- Huang, L.; Zhang, H.; Wu, P.; Entwistle, S.; Li, X.; Yohe, T.; Yi, H.; Yang, Z.; Yin, Y. dbCAN-seq: A database of carbohydrate-active enzyme (CAZyme) sequence and annotation. Nucleic Acids Res. 2018, 46, D516–D521. [Google Scholar] [CrossRef]
- Xiang, Q.; Li, J.; Qin, P.; He, M.; Yu, X.; Zhao, K.; Zhang, X.; Ma, M.; Chen, Q.; Chen, X.; et al. Identification and evaluation of reference genes for qRT-PCR studies in Lentinula edodes. PLoS ONE 2018, 13, e0190226. [Google Scholar] [CrossRef]
- Shang, J.J.; Xu, S.J.; Tang, L.H.; Yang, R.H.; Gong, M.; Li, Y.; Wang, Y.; Zou, G.; Wan, J.N.; Bao, D.P. Transformation of compatible mating-type genes in monokaryons triggers fruiting body development by activating mating pathways in Pleurotus eryngii. Microbiol. Spectr. 2023, 11, e0527222. [Google Scholar] [CrossRef]
- Rao, X.; Huang, X.; Zhou, Z.; Lin, X. An improvement of the 2ˆ (–delta delta CT)method for quantitative real-time polymerase chain reaction data analysis. Biostat. Bioinforma. Biomath. 2013, 3, 71–85. [Google Scholar]
- Shi, H.G.; Wei, Y.C.; Ban, X.H.; Li, J.Y. Optimization of Lentinula edodes stock culture medium by orthogonal test. North. Hortic. 2020, 19, 129–133. [Google Scholar]
- Zhang, J.S.; Niu, Y.; Zhang, L.Z.; Shan, L.; Nie, J.J.; Xu, Q.F.; Feng, W.J.; Pan, B.H. Active ingredients determination of Astragalus aqueous extract and their influence on mycelium growth of five edible fungi. Chin. Agric. Sci. Bull. 2017, 33, 43–49. [Google Scholar]
- Huang, D.L.; Xu, Y.Q.; Chen, X.K. Analysis of Radix astragali and its water extract by infrared spectroscopy. Chin. J. Spectrosc. Lab. 2012, 29, 2823–2826. [Google Scholar]
- Li, Y.; Chen, F.; Liu, X. Effects of Rosa roxburghii Tratt must on the growth, nutrient composition, and antioxidant activity of Pleurotus ostreatus mycelia. Molecules 2022, 27, 3538. [Google Scholar] [CrossRef]
- Chen, L.; Cheung, P.C. Mushroom dietary fiber from the fruiting body of Pleurotus tuber-regium: Fractionation and structural elucidation of nondigestible cell wall components. J. Agric. Food Chem. 2014, 62, 2891–2899. [Google Scholar] [CrossRef]
- Elisashvili, V.; Penninckx, M.; Kachlishvili, E.; Tsiklauri, N.; Metreveli, E.; Kharziani, T.; Kvesitadze, G. Lentinula edodes and Pleurotus species lignocellulolytic enzymes activity in submerged and solid-state fermentation of lignocellulosic wastes of different composition. Bioresour. Technol. 2008, 99, 457–462. [Google Scholar] [CrossRef]
- Kaur, K.; Sharma, A.; Capalash, N.; Sharma, P. Multicopper oxidases: Biocatalysts in microbial pathogenesis and stress management. Microbiol. Res. 2019, 222, 1–13. [Google Scholar] [CrossRef]
- Leonowicz, A.; Cho, N.S.; Luterek, J.; Wilkolazka, A.; Wojtas-Wasilewska, M.; Matuszewska, A.; Hofrichter, M.; Wesenberg, D.; Rogalski, J. Fungal laccase: Properties and activity on lignin. J. Basic Microbiol. 2001, 41, 185–227. [Google Scholar] [CrossRef]
- Elisashvili, V.; Kachlishvili, E.; Penninckx, M. Effect of growth substrate, method of fermentation, and nitrogen source on lignocellulose-degrading enzymes production by white-rot basidiomycetes. J. Ind. Microbiol. Biotechnol. 2008, 35, 1531–1538. [Google Scholar] [CrossRef]
- Janusz, G.; Kucharzyk, K.H.; Pawlik, A.; Staszczak, M.; Paszczynski, A.J. Fungal laccase, manganese peroxidase and lignin peroxidase: Gene expression and regulation. Enzym. Microb. Technol. 2013, 52, 1–12. [Google Scholar] [CrossRef]
- Yang, R.H.; Li, Y.; Wu, Y.Y.; Tang, L.H.; Shang, J.J.; Bao, D.P. Comparative genomic analysis of lignocellulolytic enzymes in different Lentinula edodes strains. Acta Edulis Fungi 2018, 25, 15–22. [Google Scholar]
- Wang, J.L.; Zhu, G.Q.; Chen, Y.F.; Wang, H.Y. Research progress on extracellular degrading enzymes of several edible fungi. G. Agric. Sci. 2023, 51, 112–119. [Google Scholar]

Disclaimer/Publisher’s Note: The statements, opinions and data contained in all publications are solely those of the individual author(s) and contributor(s) and not of MDPI and/or the editor(s). MDPI and/or the editor(s) disclaim responsibility for any injury to people or property resulting from any ideas, methods, instructions or products referred to in the content. |
© 2024 by the authors. Licensee MDPI, Basel, Switzerland. This article is an open access article distributed under the terms and conditions of the Creative Commons Attribution (CC BY) license (https://creativecommons.org/licenses/by/4.0/).
Share and Cite
Chen, Z.; Yang, R.; Li, Y.; Tang, L.; Xiong, H.; Bao, D.; Guo, T. Transcriptome Analysis of the Growth-Promoting Effect of Large Macrofungal Sclerotium Powder on Lentinula edodes and Pleurotus eryngii Strains. J. Fungi 2024, 10, 808. https://doi.org/10.3390/jof10120808
Chen Z, Yang R, Li Y, Tang L, Xiong H, Bao D, Guo T. Transcriptome Analysis of the Growth-Promoting Effect of Large Macrofungal Sclerotium Powder on Lentinula edodes and Pleurotus eryngii Strains. Journal of Fungi. 2024; 10(12):808. https://doi.org/10.3390/jof10120808
Chicago/Turabian StyleChen, Zhanghu, Ruiheng Yang, Yan Li, Lihua Tang, Huiyang Xiong, Dapeng Bao, and Ting Guo. 2024. "Transcriptome Analysis of the Growth-Promoting Effect of Large Macrofungal Sclerotium Powder on Lentinula edodes and Pleurotus eryngii Strains" Journal of Fungi 10, no. 12: 808. https://doi.org/10.3390/jof10120808
APA StyleChen, Z., Yang, R., Li, Y., Tang, L., Xiong, H., Bao, D., & Guo, T. (2024). Transcriptome Analysis of the Growth-Promoting Effect of Large Macrofungal Sclerotium Powder on Lentinula edodes and Pleurotus eryngii Strains. Journal of Fungi, 10(12), 808. https://doi.org/10.3390/jof10120808
